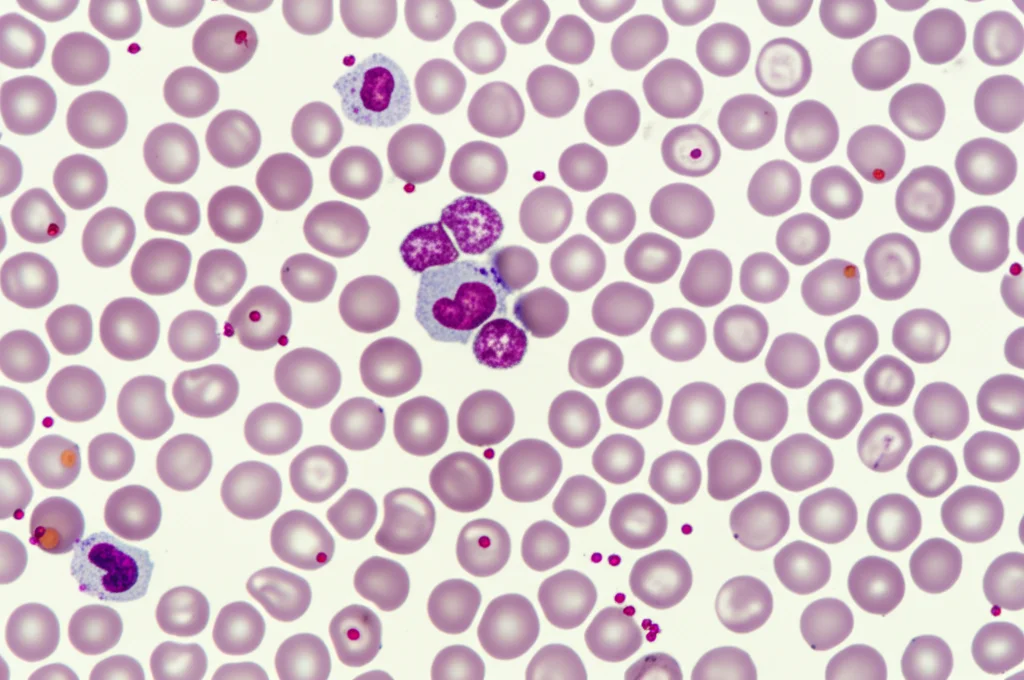
Immagine macro di cellule del sangue in una provetta o su un vetrino da microscopio, con alcune cellule evidenziate o alterate. Illuminazione controllata da laboratorio, obiettivo macro 100mm, alta definizione dei dettagli cellulari.

Linfoma Mantellare Recidivato: Doppia o Tripla Terapia Mirata? Facciamo il Punto su BTKi e Venetoclax
Ciao a tutti! Oggi voglio parlarvi di un argomento tosto ma fondamentale nel campo dell’ematologia: il trattamento del linfoma mantellare (MCL) quando, purtroppo, ritorna o non risponde più alle cure iniziali (quello che noi chiamiamo “recidivato o refrattario”, R/R). È una sfida bella grossa, ve lo assicuro, ma la ricerca non si ferma mai e oggi abbiamo nuove frecce al nostro arco.
Il Linfoma Mantellare: Un Nemico Ostico
Prima di tuffarci nelle terapie, capiamo chi abbiamo di fronte. Il linfoma mantellare è un tipo di linfoma non-Hodgkin a cellule B, spesso caratterizzato da una particolare traslocazione cromosomica, la t(11;14), che porta a un’eccessiva produzione della proteina ciclina D1. Questo lo rende piuttosto aggressivo e, nonostante i progressi con la chemioimmunoterapia, la maggior parte dei pazienti prima o poi sperimenta una ricaduta. La situazione si complica ulteriormente nei casi ad “alto rischio”, dove la malattia è particolarmente tenace a causa di instabilità genomica e vie patogenetiche multiple. Insomma, non è un avversario facile.
Nuove Armi: Inibitori di BTK e Venetoclax
Qui entrano in gioco le terapie mirate, farmaci intelligenti progettati per colpire specifici punti deboli delle cellule tumorali. Due protagonisti in questo scenario sono:
- Inibitori della tirosin-chinasi di Bruton (BTKi): Questi farmaci bloccano un enzima (BTK) cruciale per la sopravvivenza e la proliferazione delle cellule B tumorali. Hanno già cambiato la storia del trattamento dell’MCL R/R.
- Venetoclax: Questo è un inibitore di BCL-2, una proteina che impedisce alle cellule tumorali di andare incontro a morte programmata (apoptosi). Bloccando BCL-2, venetoclax aiuta a eliminare le cellule maligne.
Studi preclinici e clinici iniziali hanno suggerito che usare questi due farmaci insieme (BTKi + venetoclax) potrebbe essere una mossa vincente, grazie a un effetto sinergico. Ma funzionano davvero così bene nel mondo reale, fuori dagli studi clinici controllati? E se aggiungessimo anche un terzo “compagno di squadra”, un anticorpo monoclonale anti-CD20 (come rituximab o obinutuzumab), che aiuta il sistema immunitario a riconoscere e distruggere le cellule tumorali?
Lo Studio Cinese: Cosa Abbiamo Scoperto?
Per rispondere a queste domande, voglio parlarvi di uno studio retrospettivo molto interessante condotto in Cina su 49 pazienti con MCL R/R, trattati tra il 2018 e il 2022. Questi non erano pazienti “facili”: l’età mediana era 62 anni, avevano già ricevuto in media 3 linee di terapia precedenti e presentavano molte caratteristiche di alto rischio (Ki-67 elevato, istologia blastoide/pleomorfa, indice prognostico MIPI alto, cariotipo complesso, mutazioni di TP53 – un gene importantissimo per il controllo tumorale). Quasi due terzi avevano avuto una progressione della malattia entro 24 mesi (POD24), un altro segno di aggressività.
I pazienti sono stati trattati con una combinazione di un BTKi (ibrutinib, zanubrutinib o orelabrutinib) e venetoclax (a un dosaggio di 200 mg al giorno, inferiore a quello usato in alcuni studi occidentali, principalmente per motivi di costo e tollerabilità). Una parte di loro (circa due terzi) ha ricevuto anche un anticorpo anti-CD20 (obinutuzumab o rituximab).
I risultati? Davvero incoraggianti!
- La risposta globale (ORR), cioè la percentuale di pazienti che hanno avuto una riduzione significativa del tumore, è stata del 67.4%.
- Ancora meglio, la remissione completa (CR), cioè la scomparsa di tutti i segni del tumore, è stata raggiunta dal 53.1% dei pazienti.
- A 3 anni, la sopravvivenza libera da progressione (PFS) era del 37.5% e la sopravvivenza globale (OS) del 50.8%.
Questi numeri sono notevoli, considerando quanto fossero “difficili” questi pazienti sulla carta. La combinazione ha dimostrato di poter funzionare bene anche in presenza di fattori di alto rischio come mutazioni di TP53 o istologia aggressiva.

Terapia Doppia o Tripla? Il Dilemma dell’Anticorpo Anti-CD20
Una delle domande chiave era: aggiungere l’anticorpo anti-CD20 fa davvero la differenza? In questo studio, confrontando il gruppo che ha ricevuto la terapia doppia (BTKi + venetoclax) con quello che ha ricevuto la tripla (BTKi + venetoclax + anti-CD20), non sono emerse differenze statisticamente significative né in termini di risposta (ORR e CR) né di sopravvivenza (PFS e OS). Anzi, la percentuale di remissioni complete era leggermente, ma non significativamente, più alta nel gruppo della terapia doppia (70.6% vs 43.8%). Tuttavia, la sopravvivenza libera da progressione a 3 anni mostrava un trend a favore della tripla combinazione (45.4% vs 21.1%), anche se la differenza non ha raggiunto la significatività statistica (p=0.666).
Cosa significa? Che, almeno in questo gruppo di pazienti e con questo disegno di studio, l’aggiunta dell’anti-CD20 non ha fornito un vantaggio netto e dimostrabile. Potrebbe esserci un effetto sinergico, come suggerito dal trend sulla PFS, ma servirebbero studi prospettici randomizzati più ampi per confermarlo e capire se vale la pena aggiungere un terzo farmaco (con potenziali costi e tossicità aggiuntivi).
Chi Risponde Meglio? Fattori Chiave e Pazienti ad Altissimo Rischio
Lo studio ha anche cercato di capire quali fattori influenzassero l’esito della terapia. Un dato molto importante è emerso riguardo all’uso precedente di BTKi:
- I pazienti che non avevano mai usato un BTKi prima di questa combinazione hanno avuto risultati nettamente migliori: 100% di ORR, 77.8% di CR e una sopravvivenza a 3 anni (PFS e OS) del 100%!
- Chi era diventato refrattario a un BTKi precedente ha risposto molto meno (ORR 46.7%, CR 26.7%) e ha avuto una sopravvivenza peggiore.
- Chi era recidivato dopo un trattamento efficace con BTKi ha avuto risultati intermedi.
Questo conferma che usare questa combinazione potente prima che si sviluppi resistenza ai BTKi dà i vantaggi maggiori.
Altri fattori prognostici negativi emersi sono stati uno stato di performance generale scadente (ECOG ≥ 2) e, per la sopravvivenza globale, la presenza di mutazioni di TP53 in combinazione con altre mutazioni ad alto rischio (come KMT2D, NSD2, CCND1, NOTCH1, CDKN2A, NOTCH2, SMARCA4). Questo gruppo “ultra-high-risk” ha mostrato una sopravvivenza globale a 3 anni significativamente peggiore (30.0% vs 76.0%) nonostante la terapia combinata, suggerendo che per loro servono strategie ancora più aggressive (come CAR-T, anticorpi bispecifici o trapianto allogenico).
E Gli Effetti Collaterali? Sicurezza e Tollerabilità
Come tutte le terapie efficaci, anche questa combinazione non è priva di effetti collaterali. I più comuni sono stati quelli ematologici:
- Neutropenia (bassi globuli bianchi neutrofili): 44.9% (grave nel 28.6%)
- Trombocitopenia (basse piastrine): 22.4% (grave nel 20.4%)
Sono state frequenti anche le infezioni polmonari (32.7%, gravi nel 14.3%), affaticamento, e infezioni severe da COVID-19 (che hanno causato 2 dei 22 decessi registrati). La sindrome da lisi tumorale, un rischio con venetoclax, si è verificata in 4 pazienti ma è stata gestita. È interessante notare che il dosaggio di venetoclax usato (200 mg/die) è più basso rispetto ad altri studi (spesso 400 mg/die), ma ha comunque mostrato buona efficacia, forse con un profilo di tossicità leggermente migliore, anche se le infezioni restano una preoccupazione importante.
Un dato preoccupante emerso è che 7 dei 19 pazienti deceduti per progressione della malattia hanno sviluppato un coinvolgimento secondario del sistema nervoso centrale (SNC). Questo è un fenomeno raro ma grave nell’MCL, e il fatto che sia emerso dopo resistenza a questa potente combinazione suggerisce che la malattia possa diventare ancora più aggressiva e capace di superare la barriera emato-encefalica. Questo richiede attenzione e monitoraggio specifici nei pazienti che progrediscono.
Cosa Portiamo a Casa? Messaggi Chiave
Insomma, cosa ci dice questo studio “dal mondo reale”?
- La combinazione di BTKi e venetoclax (anche a dosaggio ridotto di venetoclax) è efficace nel linfoma mantellare R/R, portando a risposte profonde e durature in una buona percentuale di pazienti, anche quelli con caratteristiche di alto rischio.
- L’aggiunta di un anticorpo anti-CD20 (terapia tripla) non ha mostrato un chiaro vantaggio statisticamente significativo rispetto alla terapia doppia in questo studio, anche se un possibile beneficio sulla durata della risposta non può essere escluso e merita ulteriori indagini.
- Usare questa combinazione precocemente, prima che il paziente diventi resistente ai BTKi, offre i risultati migliori.
- I pazienti con un profilo di rischio “ultra-alto” (TP53 mutato + altre mutazioni specifiche) rimangono una sfida e probabilmente necessitano di approcci terapeutici diversi o più intensi.
- La gestione della tossicità, in particolare quella ematologica e il rischio infettivo, è fondamentale.
- Il rischio di coinvolgimento del SNC dopo fallimento di questa terapia combinata è un aspetto nuovo e preoccupante che richiede attenzione clinica e ulteriori ricerche.
Questo studio aggiunge un tassello importante alla nostra comprensione di come trattare al meglio il linfoma mantellare R/R nel mondo reale. Ci conferma la potenza delle terapie mirate combinate e ci aiuta a definire meglio quali pazienti ne beneficiano di più e quali potrebbero aver bisogno di strategie alternative. La strada è ancora lunga, ma ogni passo avanti ci avvicina a offrire cure sempre più personalizzate ed efficaci!
Fonte: Springer







